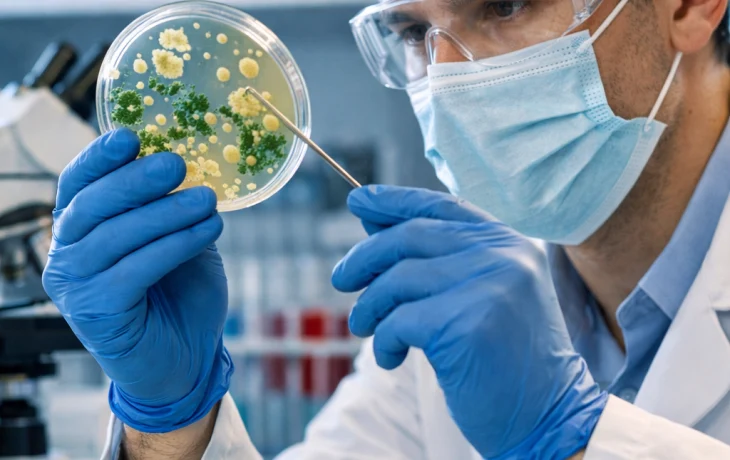
В России раскрыли тайный механизм защиты бактерий

В России раскрыли тайный механизм защиты бактерий
Российские исследователи из Пермского национального исследовательского политехнического университета (ПНИПУ) совместно с учёными Института экологии и генетики микроорганизмов УрО РАН выявили ранее неизвестный механизм защиты бактерий, который помогает микроорганизмам выживать в экстремальных условиях. Открытие было сделано в ходе экспериментов с кишечной палочкой и может стать основой для создания новых, более эффективных антибиотиков. О результатах исследования сообщили в пресс-службе университета, информацию распространило агентство ТАСС.
В ходе работы ученые искусственно создали для бактерий критическую среду, лишив их азота — ключевого элемента, необходимого для синтеза ДНК, белков и нормального клеточного деления. В результате рост кишечной палочки полностью остановился, однако внутренние биохимические процессы в клетке продолжались. Это позволило исследователям детально изучить, какие механизмы активируются в условиях сильного стресса и как микроорганизм поддерживает жизнеспособность даже без возможности размножения.
Анализ показал, что ключевую роль в защите бактерии играет глутатион — особая молекула-антиоксидант, выполняющая функцию биохимического «щита». При стрессе в клетке начинают накапливаться токсичные соединения, в том числе цистеин, который запускает образование смертоносного сероводорода. Именно этот газ способен разрушать клеточные структуры и приводить к гибели микроорганизма. Глутатион действует как защитный буфер: он связывает избыток цистеина, удерживает токсичные вещества внутри безопасных химических комплексов и предотвращает разрушение клетки.
Для сравнения ученые изучили поведение сенной палочки и обнаружили, что у неё подобного механизма защиты нет. Это означает, что разные виды бактерий используют принципиально различные стратегии выживания. Если микроорганизм содержит глутатион, он может «пережидать» неблагоприятные условия, практически не теряя жизнеспособности. Если же глутатиона нет, бактерия вынуждена включать аварийные биохимические реакции, которые в итоге приводят к саморазрушению клетки.
По словам исследователей, это открытие имеет не только фундаментальное, но и прикладное значение. Оно объясняет, почему одни бактерии устойчивы к стрессам и лекарствам, а другие — погибают значительно быстрее. В перспективе эти данные могут быть использованы для создания новых антибиотиков и модернизации существующих препаратов. В частности, лекарства можно будет наделять свойствами, блокирующими синтез глутатиона или нарушающими реакции превращения токсинов в сероводород. Лишённые своей природной защиты бактерии станут более уязвимыми, а лечение инфекционных заболеваний — более эффективным и быстрым.
Таким образом, открытие пермских ученых открывает путь к разработке принципиально новых стратегий борьбы с бактериальными инфекциями и может стать важным шагом в решении проблемы устойчивости микроорганизмов к антибиотикам.